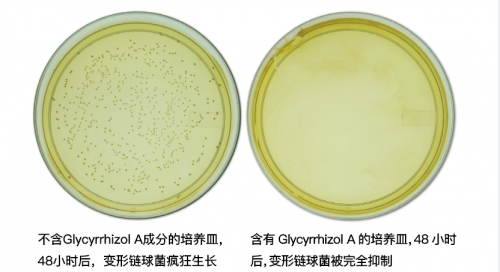

《天天向上》组了一个牙医局,邀请了资深的专业牙医团队,对我这种牙齿问题不断、孩子也需要口腔防护的人来说可是刚需!第一时间蹲直播~

结果,就这样被宝藏男孩陈延迪安利了!
很多人认识陈延迪应该是从《心动的信号 》开始,节目中他干净阳光,风趣幽默,最强记忆点应该是他的神秘身份了!
原来小迪是牙科排名第一的四川大学华西口腔医学院的博士,并在华西口腔医院担任儿童牙医。

陈延迪在节目中分享,为了鼓励小朋友配合治疗,他会送小朋友一些橡皮擦、贴纸、棒棒糖之类的小东西,帮助孩子们放松下来。

牙科医生竟然会“鼓励”小朋友吃糖?
去做功课才发现,早先在某次翻包时,这支糖就已经在陈延迪的包包里亮过相了~

孩子们喜欢吃糖,这是天性。但是身为儿科牙医的他一定见过不少蛀牙了!所以能让牙医随身携带的棒棒糖怎么能是一支普通的棒棒糖?
查了才发现原来它就是可以预防龋齿的倍齿乐。


市面上宣称“牙齿友好型”的糖果很多,想挑选一款最适合孩子成长期食用的棒棒糖,除了科学的成分配方,还需要严谨的实验数据辅助。而恰好倍齿乐刚进入国内,就是在华西口腔做注册登记和相关的实验研究。

碰巧,就是这款棒棒糖,符合他所有的要求。这篇学术论文中陈的观点和结论也是依据倍齿乐棒棒糖的实验结果得来的。

说到底,这款棒棒糖到底有什么魔力,征服了专业的牙科医生?

倍齿乐棒棒糖是美国著名口腔生物学家在牙科研究所中孕育出来的。他试验了2000多种材料,终于发现一种甘草提取物,可以有效抑制变形链球菌。而甘草提取物就是倍齿乐棒棒糖预防龋齿的特殊成分。
科学家为了验证甘草提取物的有效性,模仿了人类的口腔环境,在两个培养皿中加入适量变形链球菌,做了一个有趣的实验:
结果 48 小时后
左边没有甘草提取物的培养皿,变形链球菌疯狂生长,达到肉眼可见的程度;
右边加入了甘草提取物的培养皿,变形链球菌不但没有生长,反而被有效抑制。
这个实验证明,含有甘草提取物的 Little Wanddy(倍齿乐)棒棒糖,确实能有效抑制口腔内导致龋齿的变形链球菌的数量。
倍齿乐刚刚引进国内的时候,就在国内口腔排名前 3 的华西口腔医院做过临床实验,用实力征服了大家。并且中华口腔医学委员会主委邹静,在做教育节目《医说》时还公开推荐过“可以预防龋齿”的倍齿乐。

华西口腔医院儿童口腔科教授、主任邹静主任,在中国教育电视台的《医说》节目担任节目主讲嘉宾,讲述关于儿童口腔的预防科普工作时,推荐了倍齿乐防龋棒棒糖。
不止陈延迪,这份华西口腔的学术研究还引起了口腔医疗界很多医生学者的兴趣,比如营养学家顾中一,婴幼儿专家崔玉涛等等,而且最终都得到了他们的肯定;

除了专业版倍齿乐,他们家还有一款VC无糖棒棒糖,它同样符合国内无糖检测标准,并且添加了维生素 C 和膳食纤维,大人小孩儿都能吃,小红薯们的分享还挺多呢!

Little wanddy倍齿乐为想要给宝宝护齿的妈妈们提供了更多选择。如果你正在为孩子蛀牙苦恼,可以试试看。